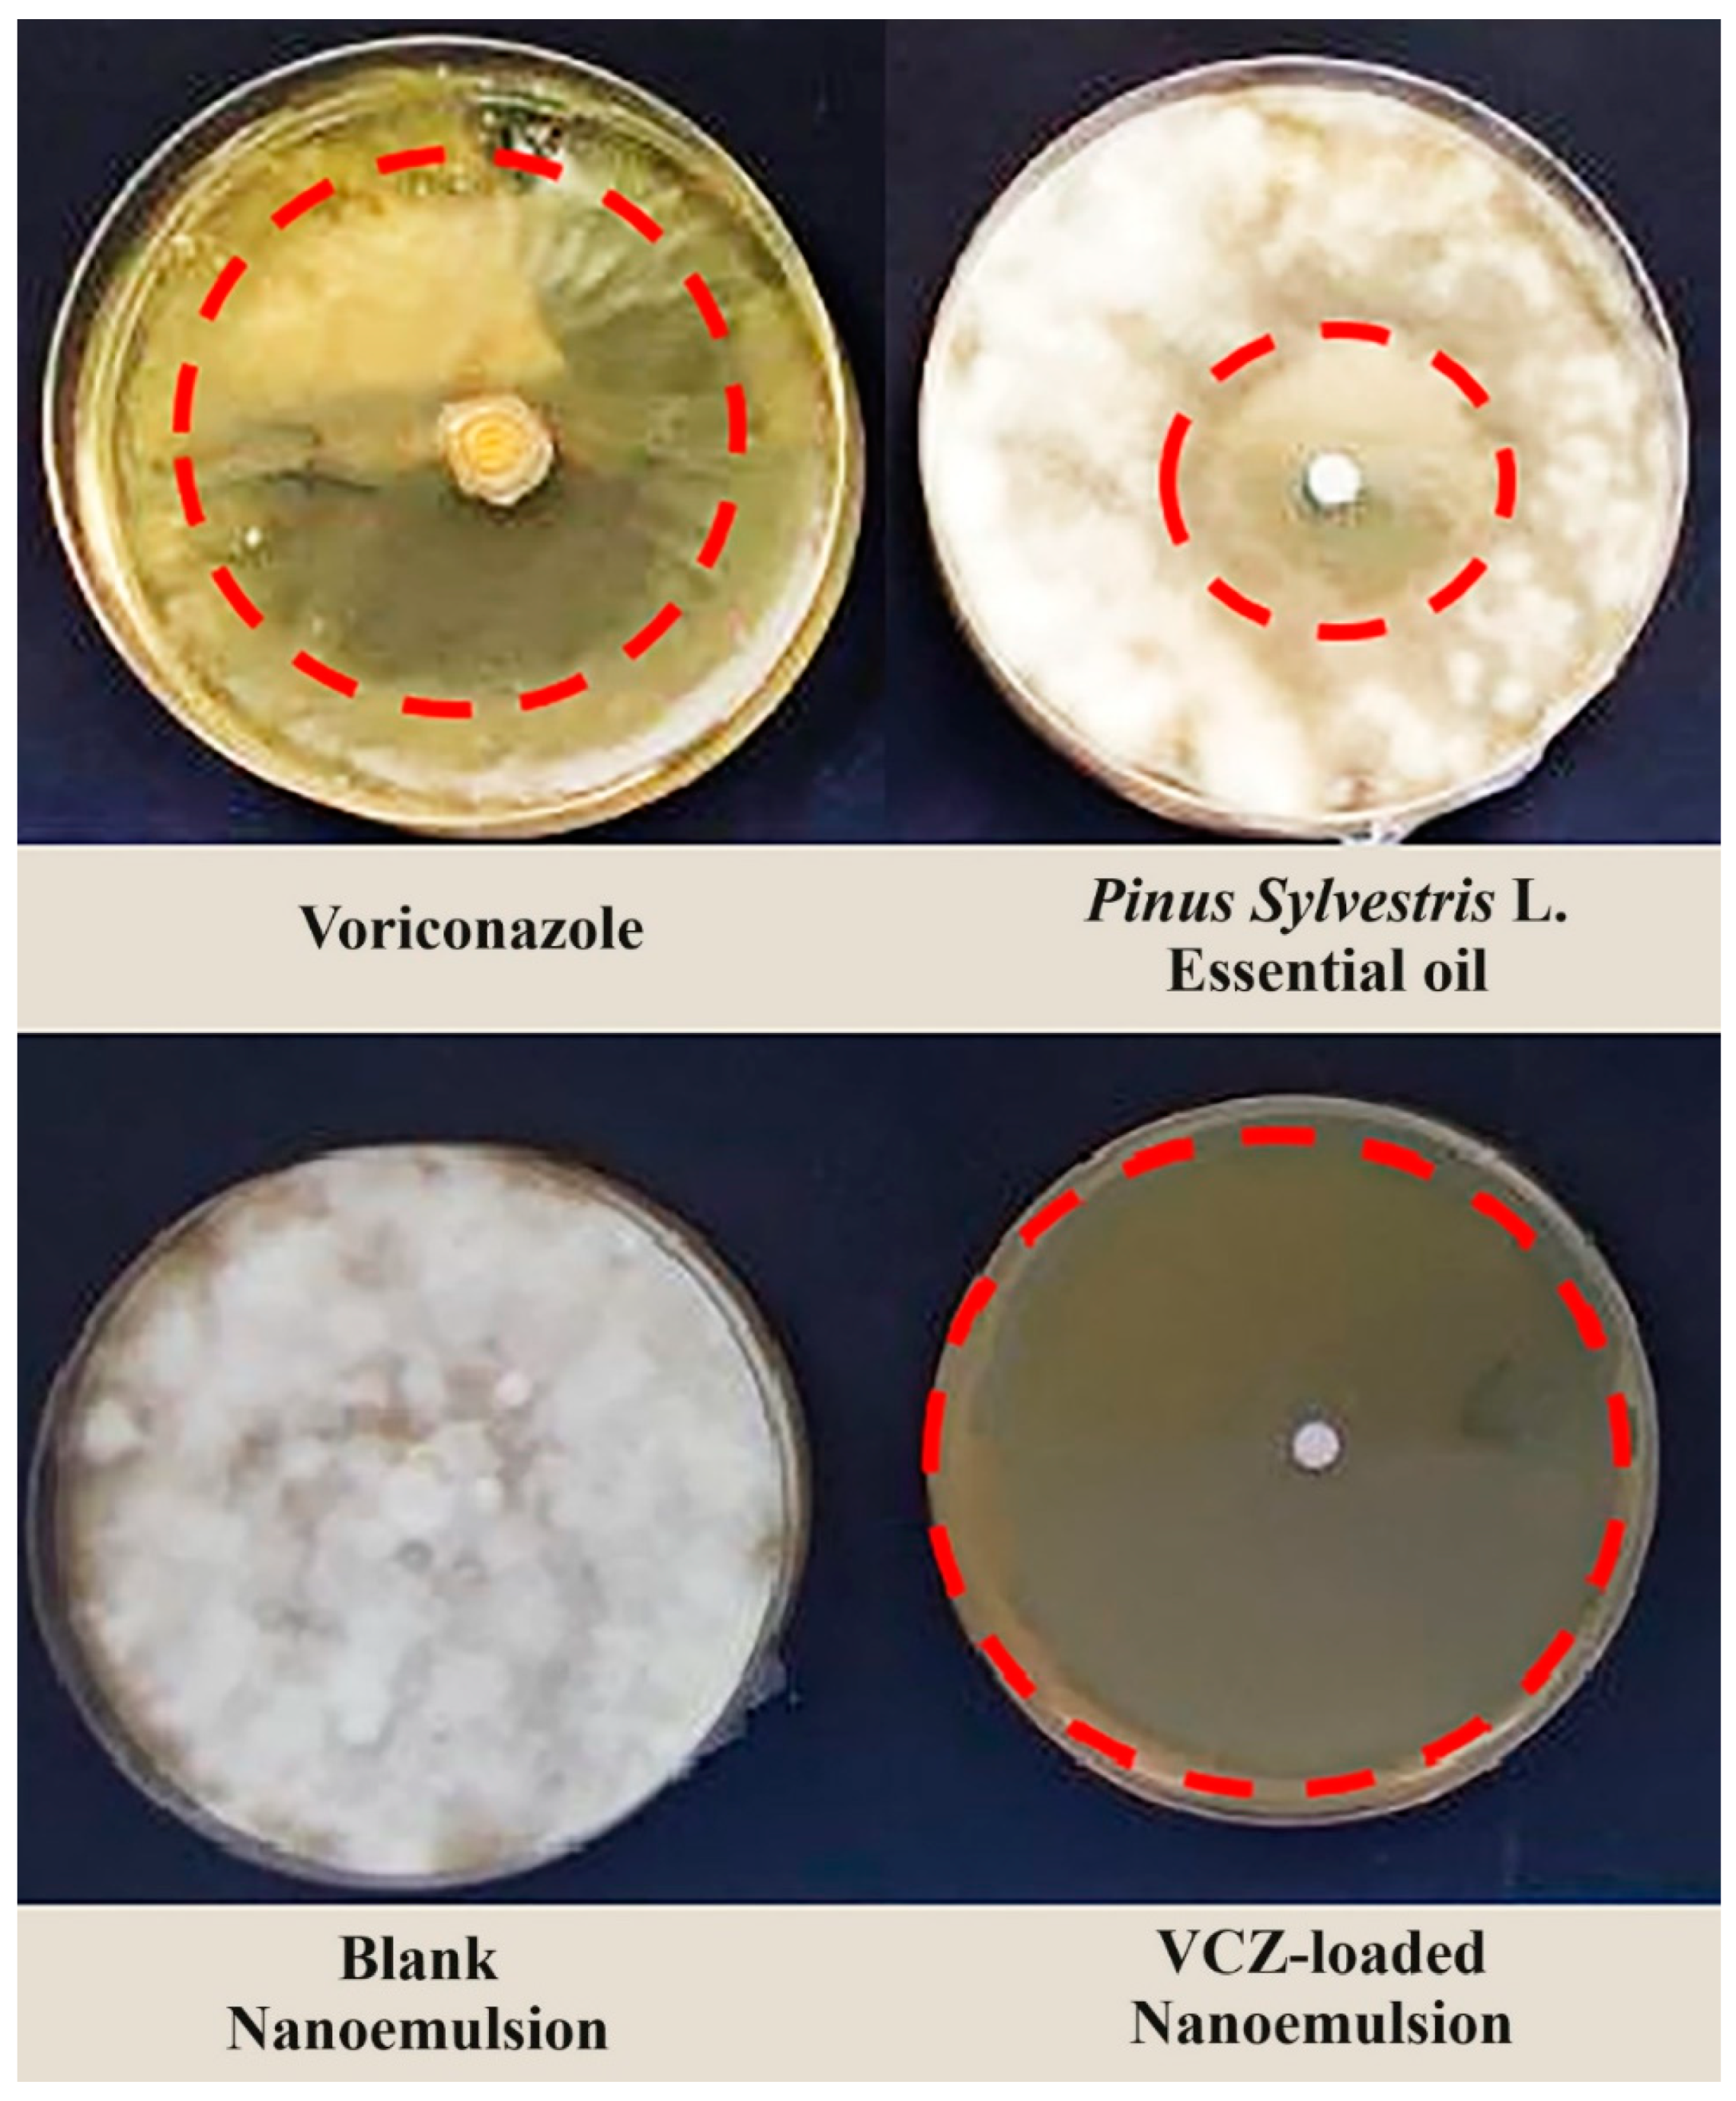
Colloids 08 00056 g006

Exploring the Antifungal Effectiveness of a Topical Innovative Formulation Containing Voriconazole Combined with Pinus sylvestris L. Essential Oil for Onychomycosis
Abstract
1. Introduction
2. Materials and Methods
2.1. Drug and Chemical Reagents
2.2. Formulation of VCZ-Based Nanoemulsion
2.2.1. Selection of the Oily Phase Components
2.2.2. Pseudo-Ternary Phase Diagrams
2.2.3. Nanoemulsion Optimization Using D-Optimal Mixture Design
2.3. Preparation of the Optimized Nanoemulsion
2.4. Physicochemical Characterization of the Optimal VCZ-Loaded Nanoemulsion
2.4.1. Droplet Size, PDI, and Zeta Potential Determination
2.4.2. Percentage of Transmittance
2.4.3. pH Measurement
2.5. Stability Studies
2.5.1. Stability to Centrifugation
2.5.2. Stability to Temperature Cycles
2.5.3. Stability to Freeze–Thaw Cycles
2.6. In Vitro Cytotoxicity Assay
2.6.1. Cell Culture
2.6.2. Cell Viability Assay
2.7. In Vitro Drug Permeation Studies
2.8. In Vitro Antifungal Activity
2.8.1. Fungi Strains
2.8.2. Disk Agar Diffusion Assay
3. Results
3.1. Formulation and Optimization of VCZ-Loaded Nanoemulsion
3.1.1. Pseudo-Ternary Phase Diagrams
3.1.2. Experimental Design
3.2. Characterization of the Optimal VCZ-Loaded Nanoemulsion and Stability Studies
3.3. In Vitro Cytotoxicity Assay
3.4. In Vitro Permeability Studies
3.5. In Vitro Antifungal Activity
4. Discussion
5. Conclusions
Supplementary Materials
Author Contributions
Funding
Data Availability Statement
Conflicts of Interest
References
- Ojha, A.K.; Albert, V.; Sharma, S.; Hallur, V.; Singh, G.; Pamidimukkala, U.; Singh, K.J.; Kaur, H.; Karuna, T.; Savio, J.; et al. Pan-Indian Clinical Registry of Invasive Fungal Infections Among Patients in the Intensive Care Unit: Protocol for a Multicentric Prospective Study. JMIR Res. Protoc. 2024, 13, e54672. [Google Scholar] [CrossRef]
- Chanyachailert, P.; Leeyaphan, C.; Bunyaratavej, S. Cutaneous fungal infections caused by dermatophytes and non-dermatophytes: An Updated Comprehensive Review of Epidemiology, Clinical presentations, and diagnostic testing. J. Fungi 2023, 9, 669. [Google Scholar] [CrossRef]
- Maskan Bermudez, N.; Rodríguez-Tamez, G.; Perez, S.; Tosti, A. Onychomycosis: Old and New. J. Fungi 2023, 9, 559. [Google Scholar] [CrossRef]
- Lipner, S.R.; Scher, R.K. Onychomycosis: Clinical overview and diagnosis. J. Am. Acad. Dermatol. 2019, 80, 835–851. [Google Scholar] [CrossRef]
- Sigurgeirsson, B.; Baran, R. The prevalence of onychomycosis in the global population–a literature study. J. Eur. Acad. Dermatol. Venereol. 2014, 28, 1480–1491. [Google Scholar] [CrossRef]
- Carrillo-Muñoz, A.J.; Giusiano, G.; Guarro, J.; Quindós, G.; Guardia, C.; del Valle, O.; Rodríguez, V.; Estivill, D.; Cárdenes, C.D. In vitro activity of voriconazole against dermatophytes, Scopulariopsis brevicaulis and other opportunistic fungi as agents of onychomycosis. Int. J. Antimicrob. Agents 2007, 30, 157–161. [Google Scholar] [CrossRef]
- Shirwaikar, A.; Thomas, T.; Shirwaikar, A.; Lobo, R.; Prabhu, K. Treatment of onychomycosis: An update. Indian. J. Pharm. Sci. 2008, 70, 710–714. [Google Scholar] [CrossRef]
- Gupta, A.K.; Talukder, M.; Venkataraman, M. Review of the alternative therapies for onychomycosis and superficial fungal infections: Posaconazole, fosravuconazole, voriconazole, oteseconazole. Int. J. Dermatol. 2022, 61, 1431–1441. [Google Scholar] [CrossRef]
- Nofal, A.; Fawzy, M.M.; El-Hawary, E.E. Successful treatment of resistant onychomycosis with voriconazole in a liver transplant patient. Dermatol. Ther. 2020, 33, e14014. [Google Scholar] [CrossRef]
- Axler, E.; Lipner, S.R. Antifungal Selection for the Treatment of Onychomycosis: Patient Considerations and Outcomes. Infect. Drug Resist. 2024, 17, 819–843. [Google Scholar] [CrossRef]
- de Almeida Campos, L.; Fin, M.T.; Santos, K.S.; de Lima Gualque, M.W.; Freire Cabral, A.K.L.; Khalil, N.M.; Fusco-Almeida, A.M.; Mainardes, R.M.; Mendes-Giannini, M.J.S. Nanotechnology-Based Approaches for Voriconazole Delivery Applied to Invasive Fungal Infections. Pharmaceutics 2023, 15, 266. [Google Scholar] [CrossRef]
- Scott, L.J.; Simpson, D. Voriconazole: A review of its use in the management of invasive fungal infections. Drugs 2007, 67, 269–298. [Google Scholar] [CrossRef]
- Donnelly, J.P.; De Pauw, B.E. Voriconazole-a new therapeutic agent with an extended spectrum of antifungal activity. Clin. Microbiol. Infect. 2004, 10, 107–117. [Google Scholar] [CrossRef]
- Maschmeyer, G.; Haas, A. Voriconazole: A broad spectrum triazole for the treatment of serious and invasive fungal infections. Future Microbiol. 2006, 1, 365–385. [Google Scholar] [CrossRef]
- Akkuş, İ.; Kaçmaz, B. Antifungal drugs. J. Curr. Hematol. Oncol. Res. 2023, 1, 41–46. [Google Scholar] [CrossRef]
- Poojary, S.A. Topical antifungals: A review and their role in current management of dermatophytoses. Clin. Dermatol. Rev. 2017, 1 (Suppl. 1), S24–S29. [Google Scholar] [CrossRef]
- Rathi, A.R.; Popat, R.R.; Adhao, V.S.; Shrikhande, V.N. Nail drug delivery system a review. Int J Pharm Chem Anal 2020, 7, 9–21. [Google Scholar]
- Gupta, A.K.; Polla Ravi, S.; Choi, S.Y.; Konda, A.; Cooper, E.A. Strategies for the enhancement of nail plate permeation of drugs to treat onychomycosis. J. Eur. Acad. Dermatol. Venereol. 2023, 37, 243–255. [Google Scholar] [CrossRef]
- Lang, G.; Buchbauer, G. A review on recent research results (2008–2010) on essential oils as antimicrobials and antifungals. A review. Flavour. Fragr. J. 2012, 27, 13–39. [Google Scholar] [CrossRef]
- Cannas, S.; Usai, D.; Tardugno, R.; Benvenuti, S.; Pellati, F.; Zanetti, S.; Molicotti, P. Chemical composition, cytotoxicity, antimicrobial and antifungal activity of several essential oils. Nat. Prod. Res. 2016, 30, 332–339. [Google Scholar] [CrossRef]
- Vaou, N.; Stavropoulou, E.; Voidarou, C.; Tsigalou, C.; Bezirtzoglou, E. Towards Advances in Medicinal Plant Antimicrobial Activity: A Review Study on Challenges and Future Perspectives. Microorganisms 2021, 9, 2041. [Google Scholar] [CrossRef]
- Khan, M.S.A.; Malik, A.; Ahmad, I. Anti-candidal activity of essential oils alone and in combination with amphotericin B or fluconazole against multi-drug resistant isolates of Candida albicans. Med. Mycol. 2012, 50, 33–42. [Google Scholar] [CrossRef]
- Scalas, D.; Mandras, N.; Roana, J.; Tardugno, R.; Cuffini, A.M.; Ghisetti, V.; Benvenuti, S.; Tullio, V. Use of Pinus sylvestris L. (Pinaceae), Origanum vulgare L. (Lamiaceae), and Thymus vulgaris L. (Lamiaceae) essential oils and their main components to enhance itraconazole activity against azole susceptible/not-susceptible Cryptococcus neoformans strains. BMC Complement. Altern. Med. 2018, 18, 1–13. [Google Scholar] [CrossRef]
- Wróblewska, M.; Szymańska, E.; Winnicka, K. The influence of tea tree oil on antifungal activity and pharmaceutical characteristics of Pluronic® F-127 gel formulations with ketoconazole. Int. J. Mol. Sci. 2021, 22, 11326. [Google Scholar] [CrossRef]
- Roana, J.; Mandras, N.; Scalas, D.; Campagna, P.; Tullio, V. Antifungal activity of Melaleuca alternifolia essential oil (TTO) and its synergy with itraconazole or ketoconazole against Trichophyton rubrum. Molecules 2021, 26, 461. [Google Scholar] [CrossRef]
- Motiejūnaitė, O.; Dalia Pečiulytė, D. Fungicidal properties of Pinus sylvestris L. for improvement of air quality. Medicina 2004, 8, 787–794. [Google Scholar]
- Rózalska, B.; Sadowska, B.; Wieckowska-Szakiel, M.; Budzyńska, A. [The synergism of antifungals and essential oils against Candida spp. evaluated by a modified gradient-diffusion method], Synergizm leków przeciwgrzybiczych i olejków eterycznych wobec Candida sp., oceniany zmodyfikowana metoda gradientowo-dyfuzyjna. Med. Dosw. Mikrobiol. 2011, 63, 163–169. [Google Scholar]
- Sharifzadeh, A.; Shokri, H.; Abbaszadeh, S. Interaction of carvacrol and voriconazole against drug-resistant Candida strains isolated from patients with candidiasis. J. Mycol. Med. 2019, 29, 44–48. [Google Scholar] [CrossRef]
- Chen, L.; Tan, F.; Wang, J.; Liu, F. Assessment of the percutaneous penetration of indomethacin from soybean oil microemulsion: Effects of the HLB value of mixed surfactants. Pharmazie 2012, 67, 31–36. [Google Scholar]
- Thongchai, W.; Liawruangrath, B. Development of HPLC analysis for the determination of retinol and alpha tocopherol in corn oil nanoemulsion lotion. Int. Food Res. J. 2016, 23, 1367–1371. [Google Scholar]
- Ryu, K.-A.; Park, P.J.; Kim, S.-B.; Bin, B.-H.; Jang, D.-J.; Kim, S.T. Topical delivery of coenzyme Q10-loaded microemulsion for skin regeneration. Pharmaceutics 2020, 12, 332. [Google Scholar] [CrossRef]
- Orchard, A.; van Vuuren, S.F.; Viljoen, A.M. Commercial essential oil combinations against topical fungal pathogens. Nat. Prod. Commun. 2019, 14, 1934578X1901400139. [Google Scholar] [CrossRef]
- Felšöciová, S.; Vukovic, N.; Jeżowski, P.; Kačániová, M. Antifungal activity of selected volatile essential oils against Penicillium sp. Open Life Sci. 2020, 15, 511–521. [Google Scholar] [CrossRef]
- Rasoanirina, B.N.V.; Lassoued, M.A.; Kamoun, A.; Bahloul, B.; Miladi, K.; Sfar, S. Voriconazole-loaded self-nanoemulsifying drug delivery system (SNEDDS) to improve transcorneal permeability. Pharm. Dev. Technol. 2020, 25, 694–703. [Google Scholar] [CrossRef]
- Lassoued, M.A.; Sfar, S.; Bouraoui, A.; Khemiss, F. Absorption enhancement studies of clopidogrel hydrogen sulphate in rat everted gut sacs. J. Pharm. Pharmacol. 2012, 64, 541–552. [Google Scholar] [CrossRef]
- Lassoued, M.A.; Khemiss, F.; Sfar, S. Comparative study of two in vitro methods for assessing drug absorption: Sartorius SM 16750 apparatus versus everted gut sac. J. Pharm. Pharm. Sci. 2011, 14, 117–127. [Google Scholar] [CrossRef]
- Nweze, E.I.; Mukherjee, P.; Ghannoum, M. Agar-based disk diffusion assay for susceptibility testing of dermatophytes. J. Clin. Microbiol. 2010, 48, 3750–3752. [Google Scholar] [CrossRef]
- Uzun, O.; Arikan, S.; Kocagöz, S.; Sancak, B.; Unal, S. Susceptibility testing of voriconazole, fluconazole, itraconazole and amphotericin B against yeast isolates in a Turkish University Hospital and effect of time of reading. Diagn. Microbiol. Infect. Dis. 2000, 38, 101–107. [Google Scholar] [CrossRef]
- Rowe, R.C.; Sheskey, P.; Quinn, M. Handbook of Pharmaceutical Excipients, 6th ed.; Pharmaceutical Press and American Pharmacists Association: Grayslake, IL, USA, 2009; pp. 199–200. [Google Scholar]
- Barrera-Arellano, D.; Badan-Ribeiro, A.P.; Serna-Saldivar, S.O. Corn oil: Composition, processing, and utilization. In Corn: Chemistry and Technology, 3rd ed.; Serna-Saldivar, S.O., Ed.; Woodhead Publishing and AACC International Press: Cambridge, UK, 2019; pp. 593–613. [Google Scholar]
- Osborne, D.W.; Musakhanian, J. Skin penetration and permeation properties of Transcutol®-neat or diluted mixtures. Aaps Pharmscitech 2018, 19, 3512–3533. [Google Scholar] [CrossRef]
- Séguy, L.; Groo, A.-C.; Goux, D.; Hennequin, D.; Malzert-Fréon, A. Design of non-haemolytic nanoemulsions for intravenous administration of hydrophobic APIs. Pharmaceutics 2020, 12, 1141. [Google Scholar] [CrossRef]
- Smejkal, G.; Gross, V.; Lazarev, A. Theoretical and Experimental Determinations of the Hydrophilic–Lipophilic Balance (HLB) of Representative Oils and Lecithins. Colloids Interfaces 2024, 8, 21. [Google Scholar] [CrossRef]
- Azeem, A.; Rizwan, M.; Ahmad, F.J.; Iqbal, Z.; Khar, R.K.; Aqil, M.; Talegaonkar, S. Nanoemulsion components screening and selection: A technical note. AAPS PharmSciTech 2009, 10, 69–76. [Google Scholar] [CrossRef]
- Wooster, T.J.; Labbett, D.; Sanguansri, P.; Andrews, H. Impact of microemulsion inspired approaches on the formation and destabilisation mechanisms of triglyceride nanoemulsions. Soft Matter 2016, 12, 1425–1435. [Google Scholar] [CrossRef]
- Shakeel, F.; Salem-Bekhit, M.M.; Haq, N.; Alshehri, S. Nanoemulsification improves the pharmaceutical properties and bioactivities of niaouli essential oil (Melaleuca quinquenervia L.). Molecules 2021, 26, 4750. [Google Scholar] [CrossRef]
- Ben Hadj Ayed, O.; Lassoued, M.A.; Bahloul, B.; Sfar, S. Self-emulsifying drug delivery system for improved dissolution and oral absorption of quetiapine fumarate: Investigation of drug release mechanism and in-vitro intestinal permeability. Iran. J. Pharm. Res. 2021, 20, 381. [Google Scholar]
- Pestana, K.; Formariz, T.; Franzini, C.; Sarmento, V.; Chiavacci, L.; Scarpa, M.; Egito, E.; Oliveira, A.G.d. Oil-in-water lecithin-based microemulsions as a potential delivery system for amphotericin B. Colloids Surf. B Biointerfaces 2008, 66, 253–259. [Google Scholar] [CrossRef]
- Sakeena, M.H.; Elrashid, S.M.; Munavvar, A.S.; Azmin, M.N. Effects of oil and drug concentrations on droplets size of palm oil esters (POEs) nanoemulsion. J. Oleo Sci. 2011, 60, 155–158. [Google Scholar] [CrossRef]
- Sarheed, O.; Dibi, M.; Ramesh, K.V. Studies on the effect of oil and surfactant on the formation of alginate-based O/W lidocaine nanocarriers using nanoemulsion template. Pharmaceutics 2020, 12, 1223. [Google Scholar] [CrossRef]
- Iskandar, B.; Mei, H.-C.; Liu, T.-W.; Lin, H.-M.; Lee, C.-K. Evaluating the effects of surfactant types on the properties and stability of oil-in-water Rhodiola rosea nanoemulsion. Colloids Surf. B Biointerfaces 2024, 234, 113692. [Google Scholar] [CrossRef]
- Silva, D.; Sarruf, F.; Oliveira, L.; Arêas, E.; Kaneko, T.; Consiglieri, V.; Velasco, M.; Baby, A. Influence of particle size on appearance and in vitro efficacy of sunscreens. Braz. J. Pharm. Sci. 2013, 49, 251–261. [Google Scholar] [CrossRef]
- Jaiswal, M.; Dudhe, R.; Sharma, P. Nanoemulsion: An advanced mode of drug delivery system. 3 Biotech 2015, 5, 123–127. [Google Scholar] [CrossRef]
- Bhattacharjee, S. DLS and zeta potential–what they are and what they are not? J. Control Release 2016, 235, 337–351. [Google Scholar] [CrossRef]
- Lukić, M.; Pantelić, I.; Savić, S.D. Towards optimal ph of the skin and topical formulations: From the current state of the art to tailored products. Cosmetics 2021, 8, 69. [Google Scholar] [CrossRef]
- Cheaburu-Yilmaz, C.N.; Yilmaz, O.; Aydin Kose, F.; Bibire, N. Chitosan-graft-poly (N-isopropylacrylamide)/PVA cryogels as carriers for mucosal delivery of voriconazole. Polymers 2019, 11, 1432. [Google Scholar] [CrossRef]
- Józsa, L.; Vasvári, G.; Sinka, D.; Nemes, D.; Ujhelyi, Z.; Vecsernyés, M.; Váradi, J.; Fenyvesi, F.; Lekli, I.; Gyöngyösi, A. Enhanced antioxidant and anti-inflammatory effects of self-nano and microemulsifying drug delivery systems containing curcumin. Molecules 2022, 27, 6652. [Google Scholar] [CrossRef]
- Vater, C.; Adamovic, A.; Ruttensteiner, L.; Steiner, K.; Tajpara, P.; Klang, V.; Elbe-Bürger, A.; Wirth, M.; Valenta, C. Cytotoxicity of lecithin-based nanoemulsions on human skin cells and ex vivo skin permeation: Comparison to conventional surfactant types. Int. J. Pharm. 2019, 566, 383–390. [Google Scholar] [CrossRef]
- Hirama, S.; Tatsuishi, T.; Iwase, K.; Nakao, H.; Umebayashi, C.; Nishizaki, Y.; Kobayashi, M.; Ishida, S.; Okano, Y.; Oyama, Y. Flow-cytometric analysis on adverse effects of polysorbate 80 in rat thymocytes. Toxicology 2004, 199, 137–143. [Google Scholar] [CrossRef]
- Iwase, K.; Oyama, Y.; Tatsuishi, T.; Yamaguchi, J.Y.; Nishimura, Y.; Kanada, A.; Kobayashi, M.; Maemura, Y.; Ishida, S.; Okano, Y. Cremophor EL augments the cytotoxicity of hydrogen peroxide in lymphocytes dissociated from rat thymus glands. Toxicol. Lett. 2004, 154, 143–148. [Google Scholar] [CrossRef]
- Tatsuishi, T.; Oyama, Y.; Iwase, K.; Yamaguchi, J.Y.; Kobayashi, M.; Nishimura, Y.; Kanada, A.; Hirama, S. Polysorbate 80 increases the susceptibility to oxidative stress in rat thymocytes. Toxicology 2005, 207, 7–14. [Google Scholar] [CrossRef]
- Zanatta, C.F.; Ugartondo, V.; Mitjans, M.; Rocha-Filho, P.A.; Vinardell, M.P. Low cytotoxicity of creams and lotions formulated with Buriti oil (Mauritia flexuosa) assessed by the neutral red release test. Food Chem. Toxicol. 2008, 46, 2776–2781. [Google Scholar] [CrossRef]
- Bunchongprasert, K.; Shao, J. Effect of fatty acid ester structure on cytotoxicity of self-emulsified nanoemulsion and transport of nanoemulsion droplets. Colloids Surf. B Biointerfaces 2020, 194, 111220. [Google Scholar] [CrossRef]
- Ruhl, T.; Storti, G.; Pallua, N. Proliferation, Metabolic Activity, and Adipogenic Differentiation of Human Preadipocytes Exposed to 2 Surfactants In Vitro. J. Pharm. Sci. 2018, 107, 1408–1415. [Google Scholar] [CrossRef]
- Kuropakornpong, P.; Itharat, A.; Ooraikul, B.; Loebenberg, R.; Davies, N.M. Development and optimization of Benjakul microemulsion formulations for enhancing topical anti-inflammatory effect and delivery. Res. Pharm. Sci. 2022, 17, 111–122. [Google Scholar] [CrossRef]
- Sharma, A.; Katta, C.; Bahuguna, D.; Veerabomma, H.; Mourya, A.; Jyothi, V.; Dikundwar, A.; Singh, S.; Madan, J. Voriconazole-syringic acid co-crystals reduced voriconazole-induced hepatotoxicity: In vitro and in vivo studies. J. Drug Deliv. Sci. Technol. 2023, 86, 104685. [Google Scholar] [CrossRef]
- Shaker, D.S.; Ishak, R.A.; Ghoneim, A.; Elhuoni, M.A. Nanoemulsion: A review on mechanisms for the transdermal delivery of hydrophobic and hydrophilic drugs. Sci. Pharm. 2019, 87, 17. [Google Scholar] [CrossRef]
- Preeti; Sambhakar, S.; Malik, R.; Bhatia, S.; Al Harrasi, A.; Rani, C.; Saharan, R.; Kumar, S.; Geeta; Sehrawat, R. Nanoemulsion: An emerging novel technology for improving the bioavailability of drugs. Scientifica 2023, 2023, 6640103. [Google Scholar] [CrossRef]
- Greer, N.D. Voriconazole: The Newest Triazole Antifungal Agent. Bayl. Univ. Med. Cent. Proc. 2003, 16, 241–248. [Google Scholar] [CrossRef]
- Mertas, A.; Garbusińska, A.; Szliszka, E.; Jureczko, A.; Kowalska, M.; Król, W. The influence of tea tree oil (Melaleuca alternifolia) on fluconazole activity against fluconazole-resistant Candida albicans strains. Biomed. Res. Int. 2015, 2015, 590470. [Google Scholar] [CrossRef]
- elsociova, S.; Kacaniova, M.; Horská, E.; Vukovic, N.; Hleba, L.; Petrová, J.; Rovná, K.; Stricik, M.; Hajduová, Z. Antifungal activity of essential oils against selected terverticillate penicillia. Ann. Agric. Environ. Med. 2015, 22, 38–42. [Google Scholar] [CrossRef]
- Miron, D.; Battisti, F.; Silva, F.K.; Lana, A.D.; Pippi, B.; Casanova, B.; Gnoatto, S.; Fuentefria, A.; Mayorga, P.; Schapoval, E.E. Antifungal activity and mechanism of action of monoterpenes against dermatophytes and yeasts. Rev. Bras. Farmacogn. 2014, 24, 660–667. [Google Scholar] [CrossRef]
- Sobrinho, A.C.N.; de Souza, E.B.; Marcos, F.; Albuquerque, M.R.J.R.; Bandera, P.N.; de Morais, S.M.; dos Santos Fontenelle, R.O.; de Paula Cavalcante, C.S. Cytotoxicity, antifungal and antioxidant activities of the essential oil from Eupatorium ballotifolium Kunth (Asteraceae). Afr. J. Pharm. Pharmacol. 2016, 10, 346–355. [Google Scholar]
- Zhan, J.; He, F.; Cai, H.; Wu, M.; Xiao, Y.; Xiang, F.; Yang, Y.; Ye, C.; Wang, S.; Li, S. Composition and antifungal mechanism of essential oil from Chrysanthemum morifolium cv. Fubaiju. J. Funct. Foods 2021, 87, 104746. [Google Scholar] [CrossRef]
- Taheri, P.; Soweizy, M.; Tarighi, S. Application of essential oils to control some important fungi and bacteria pathogenic on cereals. J. Nat. Pestic. Res. 2023, 6, 100052. [Google Scholar] [CrossRef]
- Nazzaro, F.; Fratianni, F.; Coppola, R.; Feo, V. Essential oils and antifungal activity. Pharmaceuticals 2017, 10, 86. [Google Scholar] [CrossRef]
- Hatice, K.; Bengü, E. Investigation of antifungal activity mechanisms of alpha-pinene, eugenol, and limonene. J. VetBio Sci. Tech. 2022, 7, 385–390. [Google Scholar]
- Mustafa, K.H.; Khorshidi, J.; Vafaee, Y.; Rastegar, A.; Morshedloo, M.R.; Hossaini, S. Phytochemical profile and antifungal activity of essential oils obtained from different Mentha longifolia L. accessions growing wild in Iran and Iraq. BMC Plant Biol. 2024, 24, 461. [Google Scholar] [CrossRef]
- da Cruz, R.P.; Castro, J.W.G.; Leite, D.O.D.; de Carvalho, N.K.G.; Almeida-Bezerra, J.W.; Pereira, R.L.S.; Rodrigues, F.F.G.; Bezerra, J.J.L.; Costa, A.R.; Mori, E.; et al. Chemical Composition and Antimicrobial Potential of Essential Oil of Acritopappus confertus (Gardner) R.M.King & H.Rob. (Asteraceae). Pharmaceuticals 2022, 15, 1275. [Google Scholar] [CrossRef]
- Albayrak, G.; Yörük, E.; Teker, T.; Sefer, Ö. Investigation of antifungal activities of myrcene on Fusarium reference strains. Arch. Microbiol. 2023, 205, 82. [Google Scholar] [CrossRef]
- Alighiri, D. Isolation and Antifungal Activity of Caryophyllene from Clove Leaf Oil (Syzygium aromaticum L.) on Mahogany Leaf Composites. Sci. Community Pharm. J. 2022, 1, 1–6. [Google Scholar]
- Domingos, L.T.S.; Pereira, F.G.; Moraes, D.C.d.; Marquete, R.; Rocha, M.E.d.N.; Moreira, D.d.L.; Mansur, E.; Ferreira-Pereira, A. Casearia sylvestris essential oil and its fractions inhibit Candida albicans ABC transporters related to multidrug resistance (MDR). Rodriguésia 2020, 72, e00432020. [Google Scholar] [CrossRef]



) and optimized nanoemulsion (
) using dialysis membrane as a model.
) and optimized nanoemulsion (
) using dialysis membrane as a model.

| Independent Variables | Predefined Levels | |
|---|---|---|
| Low (–1) | High (+1) | |
| A: percentage of Smix/CoS (% wt/wt) | 15 | 25 |
| B: percentage of water (% wt/wt) | 70 | 80 |
| C: percentage of corn oil/PSEO (% wt/wt) | 3 | 8.5 |
| Dependent Variables | Goals | |
| Y1: droplet size (nm) | Minimize | |
| Y2: polydispersity index (PDI) | Minimize | |
| Run | A | B | C | Y1 | Y2 |
|---|---|---|---|---|---|
| 1 | 17.87 | 79.13 | 3.00 | 14.63 | 0.140 |
| 2 | 19.75 | 74.75 | 5.50 | 14.62 | 0.146 |
| 3 | 19.75 | 74.75 | 5.50 | 15.02 | 0.128 |
| 4 | 19.75 | 74.75 | 5.50 | 15.34 | 0.140 |
| 5 | 25.00 | 70.00 | 5.00 | 14.47 | 0.130 |
| 6 | 15.00 | 76.50 | 8.50 | 52.83 | 0.657 |
| 7 | 19.75 | 74.75 | 5.50 | 16.10 | 0.103 |
| 8 | 17.52 | 74.73 | 7.75 | 28.75 | 0.331 |
| 9 | 19.75 | 74.75 | 5.5 | 16.13 | 0.122 |
| 10 | 17.16 | 77.22 | 5.62 | 17.39 | 0.121 |
| 11 | 24.40 | 72.60 | 3.00 | 13.69 | 0.157 |
| 12 | 15.00 | 80.00 | 5.00 | 17.68 | 0.138 |
| 13 | 22.10 | 72.30 | 5.60 | 15.42 | 0.128 |
| 14 | 21.50 | 70.00 | 8.50 | 26.72 | 0.432 |
| 15 | 20.55 | 76.45 | 3.00 | 15.09 | 0.183 |
| 16 | 19.63 | 72.44 | 7.93 | 23.53 | 0.354 |
| Solution 1 of 1 Response | Predicted Mean | Predicted Median | Std Dev | SE Pred | 95% PI Low | Data Mean | 95% PI High |
|---|---|---|---|---|---|---|---|
| Droplet size | 13.9909 | 13.9909 | 0.771359 | 2.59257 | 7.64711 | 14.4875 | 20.3347 |
| PDI | 0.15236 | 0.15236 | 0.0174139 | 0.058529 | 0.0091447 | 0.1815 | 0.295575 |
| Parameters | Results | |
|---|---|---|
| Physicochemical characterization | Macroscopic aspect | Translucent with a typical blue-shining appearance |
| Droplet size (nm) | 19.067 nm ± 0.138 nm | |
| PDI | 0.147 ± 0.010 | |
| Zeta potential (mV) | −17.433 ± 1.457 mV | |
| Percentage of transmittance (%) | 95.489% ± 0.139% | |
| pH | 5.64 ± 0.03 | |
| Stability studies | Centrifugation | Stable |
| Freeze–thaw cycles | Stable | |
| Heating–cooling cycles | Stable |
Disclaimer/Publisher’s Note: The statements, opinions and data contained in all publications are solely those of the individual author(s) and contributor(s) and not of MDPI and/or the editor(s). MDPI and/or the editor(s) disclaim responsibility for any injury to people or property resulting from any ideas, methods, instructions or products referred to in the content. |
© 2024 by the authors. Licensee MDPI, Basel, Switzerland. This article is an open access article distributed under the terms and conditions of the Creative Commons Attribution (CC BY) license (https://creativecommons.org/licenses/by/4.0/).
Share and Cite
Al-Suwaytee, S.H.M.; Ben Hadj Ayed, O.; Chaâbane-Banaoues, R.; Kosksi, T.; Shleghm, M.R.; Chekir-Ghedira, L.; Babba, H.; Sfar, S.; Lassoued, M.A. Exploring the Antifungal Effectiveness of a Topical Innovative Formulation Containing Voriconazole Combined with Pinus sylvestris L. Essential Oil for Onychomycosis. Colloids Interfaces 2024, 8, 56. https://doi.org/10.3390/colloids8050056
Al-Suwaytee SHM, Ben Hadj Ayed O, Chaâbane-Banaoues R, Kosksi T, Shleghm MR, Chekir-Ghedira L, Babba H, Sfar S, Lassoued MA. Exploring the Antifungal Effectiveness of a Topical Innovative Formulation Containing Voriconazole Combined with Pinus sylvestris L. Essential Oil for Onychomycosis. Colloids and Interfaces. 2024; 8(5):56. https://doi.org/10.3390/colloids8050056
Chicago/Turabian StyleAl-Suwaytee, Safaa Halool Mohammed, Olfa Ben Hadj Ayed, Raja Chaâbane-Banaoues, Tahsine Kosksi, Maytham Razaq Shleghm, Leila Chekir-Ghedira, Hamouda Babba, Souad Sfar, and Mohamed Ali Lassoued. 2024. "Exploring the Antifungal Effectiveness of a Topical Innovative Formulation Containing Voriconazole Combined with Pinus sylvestris L. Essential Oil for Onychomycosis" Colloids and Interfaces 8, no. 5: 56. https://doi.org/10.3390/colloids8050056
APA StyleAl-Suwaytee, S. H. M., Ben Hadj Ayed, O., Chaâbane-Banaoues, R., Kosksi, T., Shleghm, M. R., Chekir-Ghedira, L., Babba, H., Sfar, S., & Lassoued, M. A. (2024). Exploring the Antifungal Effectiveness of a Topical Innovative Formulation Containing Voriconazole Combined with Pinus sylvestris L. Essential Oil for Onychomycosis. Colloids and Interfaces, 8(5), 56. https://doi.org/10.3390/colloids8050056

